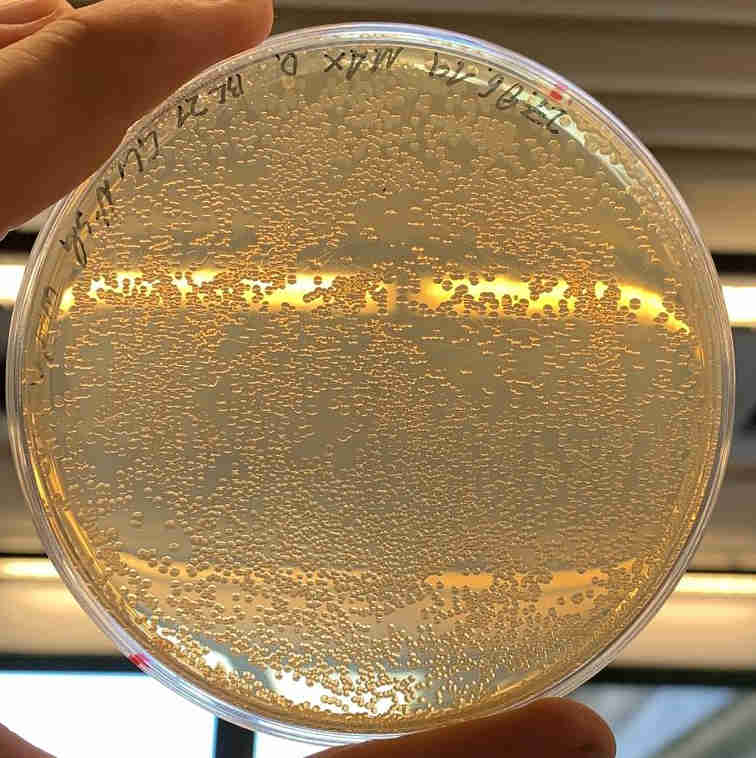

Welcome to the Huber group

Created in BioRender. Huber, E. (2025) https://BioRender.com/y21a652
Contact
PD Dr. Eva Maria Huber
Technical University of Munich
Center for Functional Protein Assemblies, room 02.037
Ernst-Otto-Fischer-Str. 8
85748 Garching b. München
Germany
Phone: +49-89-289-13354
E-Mail: eva.huber@tum.de

Funding